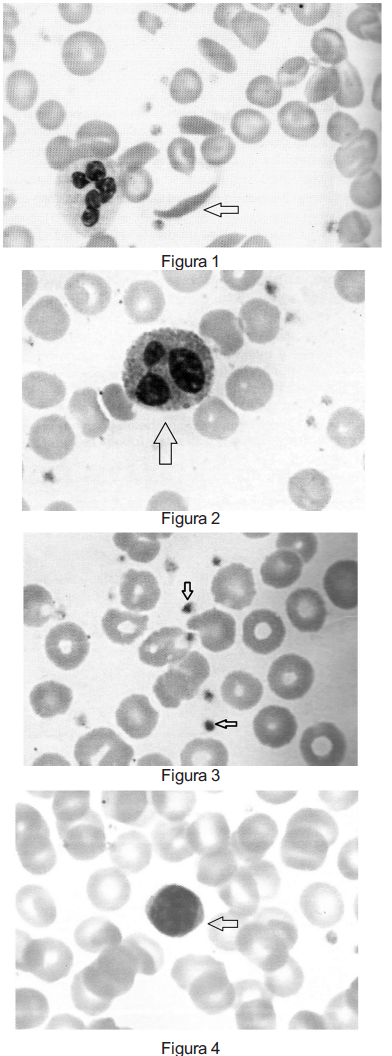
Enunciado 1092896-1

Foram encontradas 928 questões.

Provas
Provas
Provas
A toxoplasmose constitui uma doença de importância congênita. O diagnóstico precoce da toxoplasmose em gestantes e nos fetos deve ser sensível e específico, devido à possibilidade do feto apresentar lesões. Os perfis sorológicos de anticorpos anti-Toxoplasma no curso da toxoplasmose podem ser observados na figura abaixo, sendo que a linha contínua representa uma classe de imunoglobulinas e a linha descontínua representa uma outra classe de imunoglobulina de mesma especificidade antigênica.

Figura 1: Os perfis sorológicos, segundo o comportamento de anticorpos antitoxoplasma detectados pelos testes de IF-IgG, IF-IgM e HA, no curso da infecção pelo Toxoplasma gondii Pela análise do gráfico afirma-se:
I. Na fase definida na figura como perfil I ocorre produção de IgM, caracterizando a fase aguda da doença.
II. A IgG começa a ser produzida na fase definida na figura como perfil I, mas atinge seu pico na fase definida na figura como perfil II, que caracteriza fase crônica da doença.
III. Na fase definida na figura como perfil II estão presentes anticorpos capazes de atravessar a placenta.
Assinale a alternativa correta:
Provas
Ao realizar a rotina laboratorial parasitológica o biomédico verificou a presença de determinada estrutura (figura A) no exame macroscópico das fezes. Esse achado induziu o laboratorista a realizar o método de tamisação. Na realização de métodos rotineiros, ele identificou ovos nas fezes (figura B), fechando o diagnóstico da parasitose. Analise as afirmativas abaixo:

Figura A e B Características para identificação de parasitas
I. A estrutura na figura A representa uma proglote grávida.
II. O método de tamisação tem alta especificidade e sensibilidade, baseado em métodos de imunodignósticos.
III. Dentre os métodos rotineiros, técnicas de concentração da amostra de fezes, seguida de avaliação microscópica podem ter sido utilizadas para identificação da estrutura B.
Assinale a alternativa com as afirmações corretas:
Provas
Provas
Provas
Provas

0 = negativo 4+ = positivo
Provas
Provas
Caderno Container